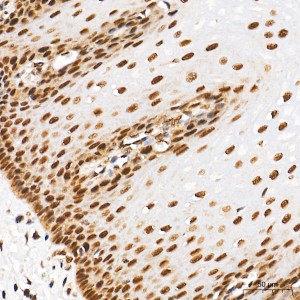
KO-Validated SUMO1 Rabbit mAb (20 μl)

| Reactivity: | Human, Mouse, Rat |
| Applications: | WB, IHC, IF/IC, ELISA |
| Host Species: | Rabbit |
| Isotype: | IgG |
| Clonality: | Monoclonal antibody |
| Gene Name: | small ubiquitin like modifier 1 |
| Gene Symbol: | SUMO1 |
| Synonyms: | DAP1; GMP1; PIC1; SMT3; UBL1; OFC10; SENP2; SMT3C; SMT3H3; O1 |
| Gene ID: | 7341 |
| UniProt ID: | P63165 |
| Clone ID: | 6F8B6 |
| Immunogen: | A synthetic peptide corresponding to a sequence within amino acids 1-101 of human Sumo 1 (P63165). |
| Dilution: | WB 1:1000-1:2000; IHC 1:2000-1:10000; IF/IC 1:200-1:400 |
| Purification Method: | Affinity purification |
| Concentration: | 0.8 mg/mL |
| Buffer: | PBS with 0.02% sodium azide, 0.05% BSA, 50% glycerol, pH7.3. |
| Storage: | Store at -20°C. Avoid freeze / thaw cycles. |
| Documents: | Manual-SUMO1 monoclonal antibody |
Background
This gene encodes a protein that is a member of the SUMO (small ubiquitin-like modifier) protein family. It functions in a manner similar to ubiquitin in that it is bound to target proteins as part of a post-translational modification system. However, unlike ubiquitin which targets proteins for degradation, this protein is involved in a variety of cellular processes, such as nuclear transport, transcriptional regulation, apoptosis, and protein stability. It is not active until the last four amino acids of the carboxy-terminus have been cleaved off. Several pseudogenes have been reported for this gene. Alternate transcriptional splice variants encoding different isoforms have been characterized.
Images
 | Western blot analysis of various lysates using [KO Validated] SUMO1 Rabbit mAb (A19121) at 1:1000 dilution. Secondary antibody: HRP-conjugated Goat anti-Rabbit IgG (H+L) (AS014) at 1:10000 dilution. Lysates/proteins: 25μg per lane. Blocking buffer: 3% nonfat dry milk in TBST. Detection: ECL Basic Kit (RM00020). Exposure time: 60s. |
 | Western blot analysis of various lysates using [KO Validated] SUMO1 Rabbit mAb (A19121) at 1:1000 dilution. Secondary antibody: HRP-conjugated Goat anti-Rabbit IgG (H+L) (AS014) at 1:10000 dilution. Lysates/proteins: 25μg per lane. Blocking buffer: 3% nonfat dry milk in TBST. Detection: ECL Basic Kit (RM00020). Exposure time: 10s. |
 | Western blot analysis of various lysates using [KO Validated] SUMO1 Rabbit mAb (A19121) at 1:1000 dilution. Secondary antibody: HRP-conjugated Goat anti-Rabbit IgG (H+L) (AS014) at 1:10000 dilution. Lysates/proteins: 25μg per lane. Blocking buffer: 3% nonfat dry milk in TBST. Detection: ECL Basic Kit (RM00020). Exposure time: 1min. |
 | Western blot analysis of lysates from wild type(WT) and SUMO1 knockout (KO) 293T cells, using [KO Validated] SUMO1 Rabbit mAb (A19121) at 1:1000 dilution. Secondary antibody: HRP-conjugated Goat anti-Rabbit IgG (H+L) (AS014) at 1:10000 dilution. Lysates/proteins: 25μg per lane. Blocking buffer: 3% nonfat dry milk in TBST. Detection: ECL Basic Kit (RM00020). Exposure time: 10s. |
 | Immunohistochemistry analysis of paraffin-embedded Human esophagus tissue using [KO Validated] SUMO1 Rabbit mAb (A19121) at a dilution of 1:5000 (40x lens). High pressure antigen retrieval performed with 0.01M Tris-EDTA Buffer (pH 9.0) prior to IHC staining. |
 | Immunohistochemistry analysis of paraffin-embedded Human tonsil tissue using [KO Validated] SUMO1 Rabbit mAb (A19121) at a dilution of 1:5000 (40x lens). High pressure antigen retrieval performed with 0.01M Tris-EDTA Buffer (pH 9.0) prior to IHC staining. |
 | Immunohistochemistry analysis of paraffin-embedded Mouse brain tissue using [KO Validated] SUMO1 Rabbit mAb (A19121) at a dilution of 1:5000 (40x lens). High pressure antigen retrieval performed with 0.01M Tris-EDTA Buffer (pH 9.0) prior to IHC staining. |
 | Immunohistochemistry analysis of paraffin-embedded Rat spleen tissue using [KO Validated] SUMO1 Rabbit mAb (A19121) at a dilution of 1:5000 (40x lens). High pressure antigen retrieval performed with 0.01M Tris-EDTA Buffer (pH 9.0) prior to IHC staining. |
You may also be interested in: